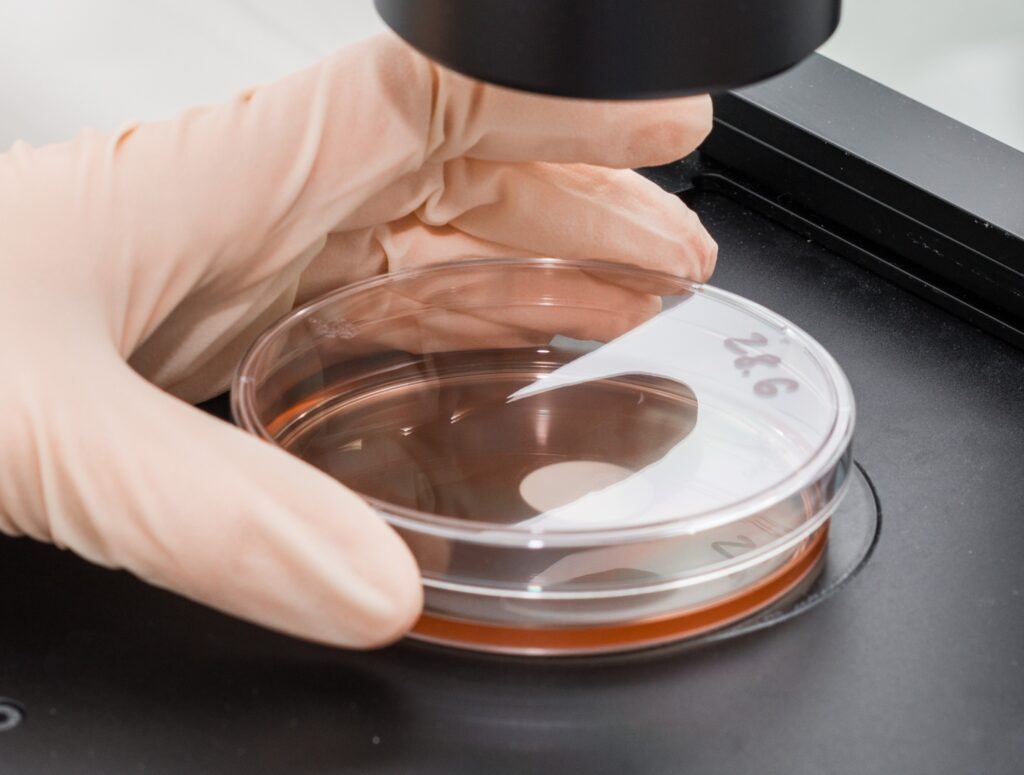

「細胞培養の完全サポートガイド」は、細胞培養に初めて挑戦する方や、まだ経験の浅い方に向けて、基礎知識や準備について解説しています。

「その1」では安全キャビネットなど無菌操作に必要な装置、「その2」ではCO2インキュベーターなど培養に必要な装置について詳しく解説しました。今回「その3」では、細胞培養に欠かせないその他の装置群を総まとめでご紹介します。具体的には、細胞を観察するための装置や、細胞や試薬を適切に保存するための装置について、なぜ必要なのか、選ぶ際のポイント、使用上の注意点などをお伝えします。
今回の「その3」で、細胞培養に必要な装置の紹介を終え、次回は「消耗品」の説明に移ります。「その1」「その2」「その3」を通して読んでいただくことで、細胞培養に必要な装置一式についての理解が深まるようになっています。ぜひまとめてご確認ください。
細胞を観察する装置
まずは「細胞を観察するための装置」から解説していきましょう。
細胞はおおよそ10~100 μmと小さく、目には見えません。しかし、培地の中で細胞たちの健康状態は良好か、ちゃんと増えているのかなどを把握しておかねばなりません。そのために、まずは小さなものを拡大して見る装置、つまり「顕微鏡」が必要です。
・倒立位相差顕微鏡
顕微鏡は、ミクロの世界を映し出してくれるだけでなく、細胞の形から状態を確認したり、細胞密度を確認したりできる、細胞培養にあたって欠かせないツールのひとつです。
細胞培養実験で使われるのは倒立位相差顕微鏡です。この顕微鏡は、「倒立型」と「位相差」という2つの機能を持っています。ではなぜこれらの機能が必要なのか、「位相差」「倒立型」の2つに分けて解説しましょう。
なぜ倒立型が必要?
倒立顕微鏡は、対物レンズが下側に配置されており、培養容器の底から細胞を観察することができます。この設計により、フラスコやディッシュに入ったまま無菌的な細胞観察が可能なためです。
なぜ位相差機能が必要?
細胞は透明で、色が付いているわけではありません。そのため、色を持たない対象を観察するために、顕微鏡が位相差機能を有している必要があります。
位相差機能とは、透明な細胞などの無染色標本に対して、光の位相差を利用してコントラストを強調する技術です。細胞を通過する光の位相の違いを検出し、それをコントラストとして強調することで、細胞の構造を明瞭に観察できます。これにより、染色せずに、生きた細胞の健康状態をリアルタイムでチェックすることが可能です。
何に使用?
細胞密度や細胞の形状の確認、コンタミの発見など、多種多様な用途に使われます。
細胞密度は、継代のタイミングを見極めるのに必要な情報ですし、また、siRNAやベクターなどを細胞内に導入するトランスフェクションでは、効率を大きく左右する条件の一つです。さらに、定期的に細胞数の増加を観察することで、細胞の増殖速度を評価することもできます。増殖が遅い場合や停止している場合は、培養条件の見直しが必要なケースも。
細胞の形から、接着細胞の剝離を確認したり、細胞の健康状態がわかったりすることもあります。また、気を付けて観察を続けることで、細菌や真菌などのコンタミの早期発見につながることもあります。もちろんコンタミが見つかった場合は直ちに対策を講じましょう。
選択時の注意点
倒立型位相差顕微鏡であれば細胞培養実験に使用できますが、モニター付きのタイプと、穴をのぞき込むモニターがないタイプが市販されています。
モニターがないタイプの顕微鏡は現在でも多くの研究者に愛用されており、直接目視で観察することで、細胞の微細な構造や動きを高い解像度で確認しやすいというメリットがあります。一方、モニター付きのタイプは、たとえば細胞の状態について同僚とディスカッションしたいときや先輩に相談したいときに、複数の人が同時に確認できるという利点があります。

図1. Invitrogen EVOS M3000 Imaging System
Invitrogen™ EVOS™ Imaging Systemは、使いやすいインターフェースで、初心者でも簡単に操作しやすい倒立型顕微鏡です。いずれのモデルにも位相差対応のレンズが搭載でき、コンパクトでPCが不要です。
シンプルなモデルのInvitrogen™ EVOS™ M3000 Imaging Systemはモニター一体型で、複数人で同時に細胞の状態を確認できます。その場で知識の共有やディスカッションができるため、問題解決がスムーズに進むかもしれません。
・セルカウンター
細胞培養実験は、細胞という「生き物」を扱う繊細な作業です。彼らの健康を管理しながら、信頼性や再現性の高いデータを得るには、さまざまな条件を整えてあげなくてはなりません。その際に重要なファクターの一つが「細胞数」です。
たとえば継代のとき、適切な細胞密度と適切なタイミングを確認するために細胞数の情報が必要ですし、核酸やタンパク質を抽出するときは細胞数を元に試薬の使用量が定められていることが多いです。
また、定期的に「細胞の生存率」を確認するのも欠かせません。細胞の健康状態が結果に大きく影響します。つまり、細胞培養実験においては、「細胞の数を数え、かつ細胞の生存率を把握できるツール」が必要です。そして、そういったツールの1つとして、セルカウンターのご用意をおすすめしています。

図2. Invitrogen Countess 3自動セルカウンター
何に使用?
細胞数のカウントや生存率の測定に使用します。
なぜセルカウンターが必要?
血球計算盤を使い、顕微鏡で細胞数を計測する方法は、歴史が長く、今日も多くの研究者によって実施されています。しかし、手作業で細胞を一つ一つ数えていくため、手間がかかり、かつ熟練度が必要という課題があります。
一方、セルカウンターは、人間の代わりに機械が細胞の数をカウントし、生存率を計算してくれます。たとえば、Invitrogen™ Countess™ 3自動セルカウンターは、トリパンブルー試薬を用いて細胞数と生存率を10秒程度で算出してくれます。このようなセルカウンターを使用することで、時間の節約だけでなく、データの精度も向上し、研究の信頼性を高めることができます。
使用上の注意点
- 測定前にしっかり懸濁
細胞はチューブの中で少しずつ沈殿していきます。慣れてくるとついつい怠りがちになるかも知れませんが、測定前にしっかり懸濁することはとても重要です。均一に懸濁された状態で測定することで、正確な細胞数を得ることができます。 - トリパンブルーの沈殿に注意
カウントのときは死細胞だけを染色するトリパンブルーがよく使われますが、トリパンブルー液中に沈殿が多く発生していると、誤カウントの原因になります。定期的にトリパンブルー溶液を確認し、沈殿がないかチェックしましょう。
参考ブログ:
・【やってみた】細胞がチューブの中で沈む速度を測ってみた
・【やってみた】沈殿だらけのトリパンブルーで自動セルカウントしてみたら誤認識されました
細胞や試薬を適切に保存する装置
次に、「細胞や試薬を適切に保存するための装置やツール」の紹介に移ります。
細胞培養実験では、試薬の冷蔵・冷凍保存だけでなく、細胞も必要に応じて凍結保存することが推奨されます。細胞を継代し続けることには、さまざまなリスクが伴うからです。継代を繰り返すうちに遺伝子変異が生じて細胞の性質が変化することがありますし、コンタミのリスクも常に付きまといます。また、実験に使用する予定のない細胞を継代し続けるのはコストや手間の面でマイナスのため、不要な細胞を保存しておくことも多いです。
これらの理由から、必要に応じて細胞を凍結保存することは、実験の再現性と信頼性を確保し、効率的な実験を実施するために重要です。これにより、長期的な研究計画を安定して実行でき、予期せぬトラブルにも柔軟に対応しやすくなります。
そして、細胞を凍結保存するときは、細胞たちをそのまま-20 ℃や-80 ℃の冷凍庫へ入れるわけにはいきません。彼らは生きているので、その生命を摘み取ってしまうことがないように、適切な方法で凍らせ、かつ適切に保管してあげる必要があります。
・Mr. Frosty凍結処理容器
では、細胞の凍結にはどのようなツールが必要なのでしょうか。
おすすめは、Thermo Scientific™ Mr.Frosty™凍結処理容器です。

図3. Thermo Scientific Mr. Frosty 凍結処理容器
何に使用?
細胞を凍結させる過程で使用します。
なぜ必要?
細胞を凍結する際によく採用される方法が、凍結保護剤を加えた状態で1 ℃/分の速度で温度を下げていく緩慢凍結法です。しかし、このスピードで凍結可能なプログラムフリーザーはなかなか高額です。
そこで登場したのがMr. Frosty凍結処理容器です。Mr. Frosty容器は、緩慢凍結法で推奨されている1 ℃/分に近い速度で、ゆっくりと細胞を凍結してくれます。
使い方は簡単で、受け容器の水位ラインまで100%イソプロピルアルコールを注ぎ、受け皿に凍結保存チューブを設置し、ふたを閉めて-80 ℃のディープフリーザーにて、最低4時間静置します。これだけで、1 ℃/分に近い冷却レートで細胞を凍結してくれます。凍結後は、チューブを液体窒素凍結保存容器に移して長期保管します。
|
― 緩慢凍結法とは? ― 細胞をゆっくりと凍結させることで、細胞内の氷晶形成を最小限に抑える方法です。 一般的に、液体を凍らせると、液中には氷晶が形成されます。細胞内の大部分は水で構成されているため、細胞を凍らせると細胞内で氷晶が形成され、細胞膜や細胞内部が破壊されてしまう可能性があります。そのため、凍結速度を落とし、かつ細胞膜透過性の凍結保護剤を加えます。凍結速度を遅くすることで、細胞外の水分が先に凍結し、浸透圧の不均衡が生じて細胞内の水が細胞外へ移動します。さらに凍結保護剤により細胞内の氷晶の形成を防ぐことで、細胞膜や細胞内部に損傷が生じるのを防ぐことができます。 なお、凍結保護剤としては10% DMSOがよく使用されます。DMSOは多くの細胞に対応していますが、別の凍結保護剤が適している細胞もありますので、細胞ごとに確認をしてください。 |
使用上の注意点
Mr. Frosty容器はあくまでも「細胞が凍結する過程で使用するツール」であり、「細胞保管容器」ではありません。そのため、細胞が凍結した後は、Mr. Frosty容器から細胞が入ったチューブを取り出し、液体窒素保管容器内に移す必要があります。
詳しくは、Mr. Frosty容器のプロトコルをご確認ください。
参考ブログ:
・【凍結保存の基礎 7】細胞の凍結冷却速度のひみつ
・理想的な冷却レートを容易に実現できる細胞凍結システム
では次に、Mr. Frosty容器で凍らせた細胞を保管するための液体窒素保存容器について説明しましょう。
・液体窒素凍結保存容器

図4. Thermo Scientific™ 液体窒素保管容器
Mr. Frosty容器にて細胞を凍結した後は、チューブをMr. Frosty容器から出し、液体窒素容器内で保存しなくてはなりません。では、なぜ核酸やタンパク質のように-20 ℃や-80 ℃での冷凍庫保管ではなく、液体窒素容器内での保管なのでしょうか。
なぜ必要?
細胞培養実験で使われる細胞は、一般的に-130 ℃以下での保管が推奨されています。
これは、-130 ℃以下という極低温では、細胞の代謝活動や化学反応がほぼ完全に停止するからです。そのため、細胞の長期保存中に起こり得る損傷や変異を最小限に抑えることができます。-20 ℃や-80 ℃では細胞の代謝活動が完全に停止しないため、長期間の保存には適していません。
使用上の注意点
細胞を含んだチューブは、気相での保存がおすすめです。
液体窒素凍結保存容器は文字通り液体窒素を保存するための容器ですが、液体窒素の冷気によって気相は約-160~-178 ℃になります(図5)。一方、液相は-196 ℃です。

図5. 一般的な液体窒素容器の温度
温度は製品や液体窒素(LN2)の量、スペースなどにより異なります。
このように液相でも気相でも細胞は保存できますが、液相だとチューブ内に液体窒素が侵入するリスクがあります。また、液相で保存するには密閉性を高める必要があり、市販のプラスチック製の凍結保存用チューブは液相保存ができないタイプも多いです。これらの理由から、細胞の保管には気相保管をおすすめしています。
参考ブログ:
・培養細胞の凍結方法と融解方法まとめ
・液体窒素環境によるサンプル保管
・冷蔵庫と冷凍庫
最後に、細胞培養に使用するさまざまな試薬を保管するための冷蔵庫や冷凍庫について説明しましょう。試薬の品質を適切に保つことは、実験結果の精度に直結します。
何に使用?
冷蔵庫は、主に培地など、細胞培養に用いる試薬類の保管に使用します。-20 ℃の冷凍庫は、主に血清や抗生物質、酵素などの保管に用います。-80 ℃の超低温冷凍庫は、細胞長期保管前の一時保存に使用することがあります。
冷蔵庫:選択時の注意点
ガラス戸のショーケースタイプの冷蔵庫は使用しないようにしましょう。蛍光灯に長期間さらされることで、培地中の成分から、細胞にとって有害な物質が生成されることがあるためです。そのため、培地は一般的に遮光保存が推奨されています。
透明ではない戸の冷蔵庫では、戸が開いている間しかライトが点灯しないため、培地をアルミホイルなどで遮光しなくても、影響がないことがほとんどです。
冷凍庫:選択時の注意点
自動霜取り機能がある冷凍庫もありますが、一時的に冷凍庫内の温度を上げてしまうため、自動霜取り機能がない冷凍庫がおすすめです。
まとめ
「細胞培養の完全サポートガイド」シリーズ、「その3」では、細胞を見守るための顕微鏡やセルカウンター、保管に必要な装置をまとめてご紹介しました。
これで、細胞培養実験に必要な装置はそろいました。あとは培地などの消耗品を用意すれば、細胞を迎える準備が完了します。ということで、次回は培地について詳しく取り上げます。
参考ブログ&サイト:
・細胞培養関連の学習リソースまとめ~トレーニング・セミナー・ハンドブックなど~
・初代細胞培養システム
Gibco™ 細胞培養ハンドブックダウンロード
研究用にのみ使用できます。診断用には使用いただけません。



